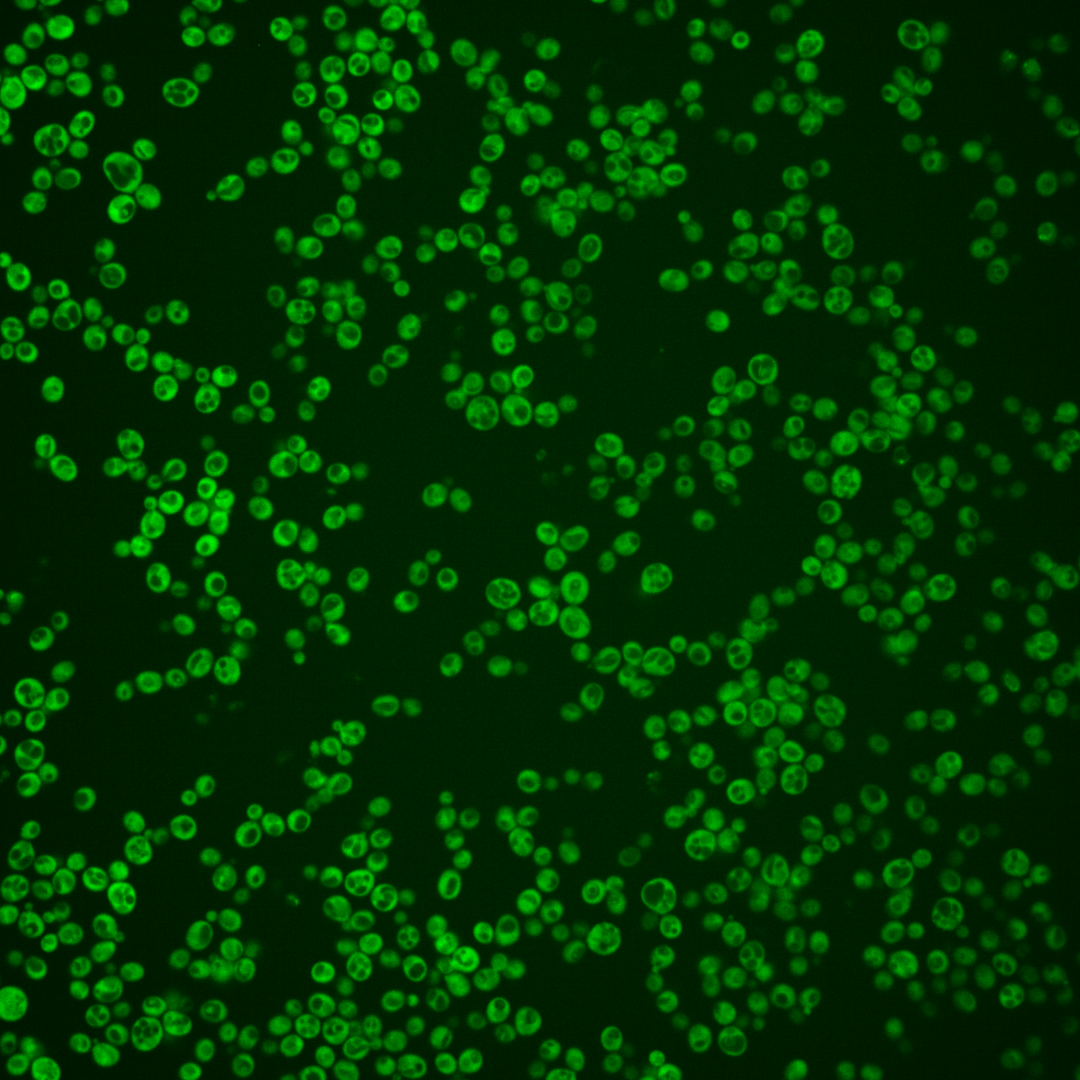
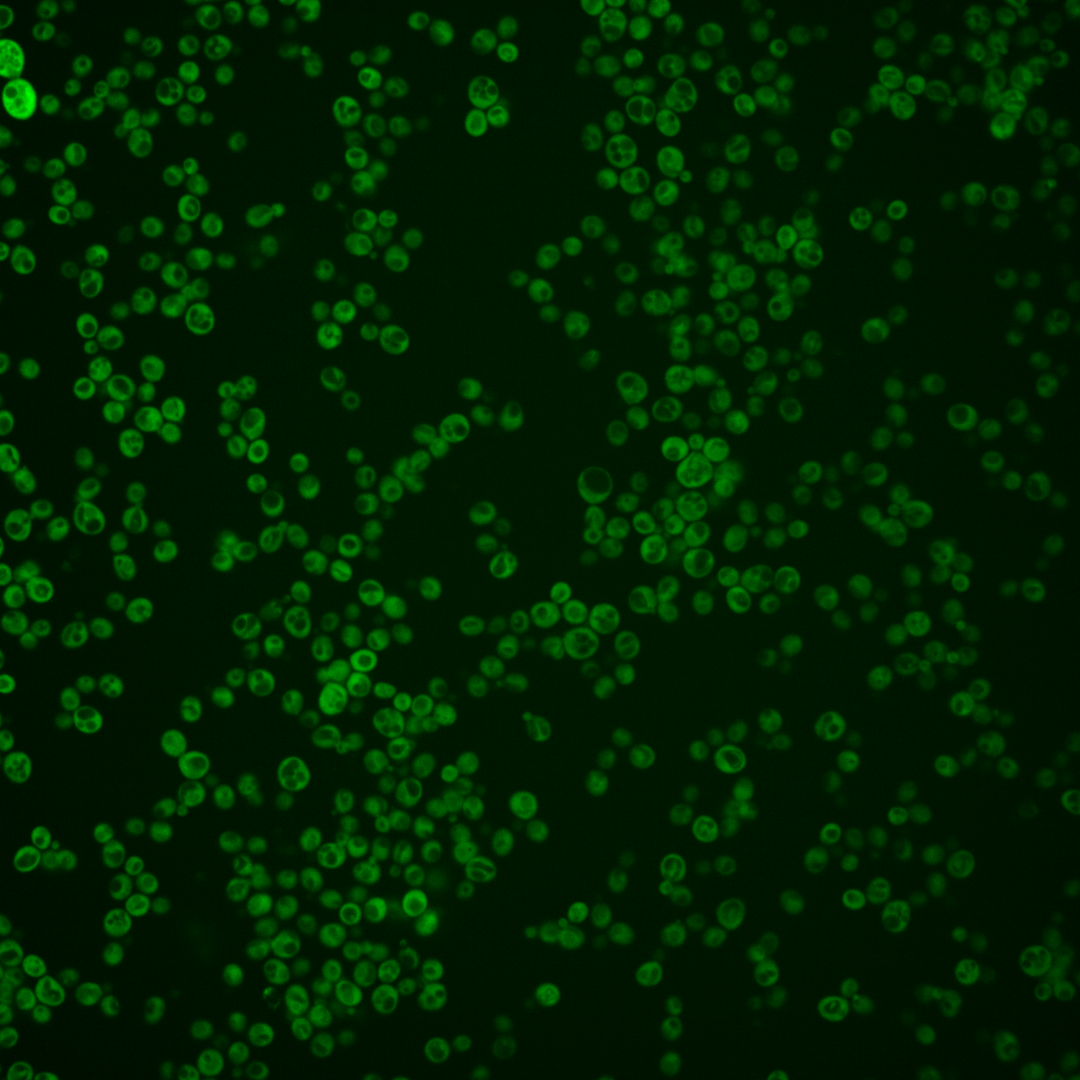
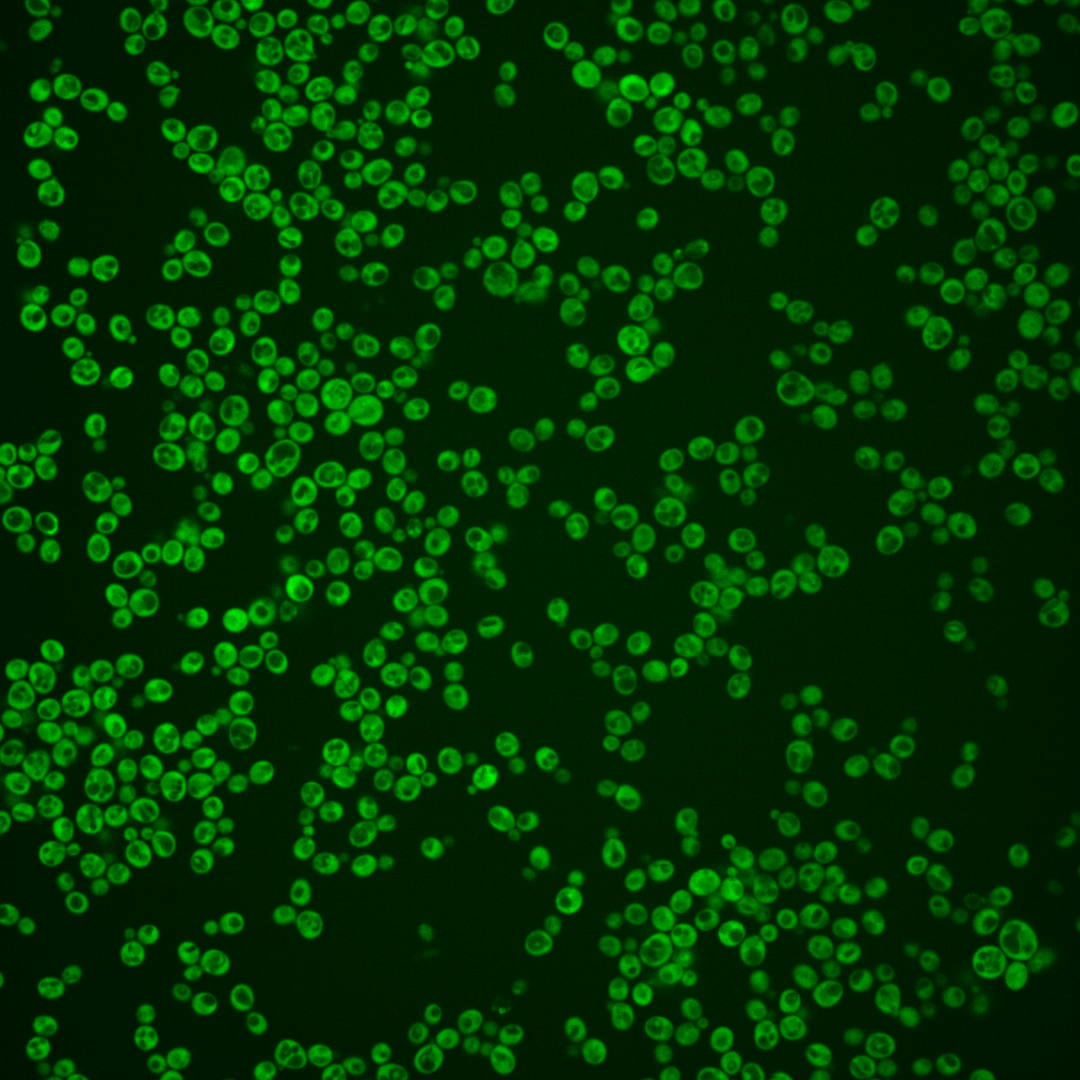
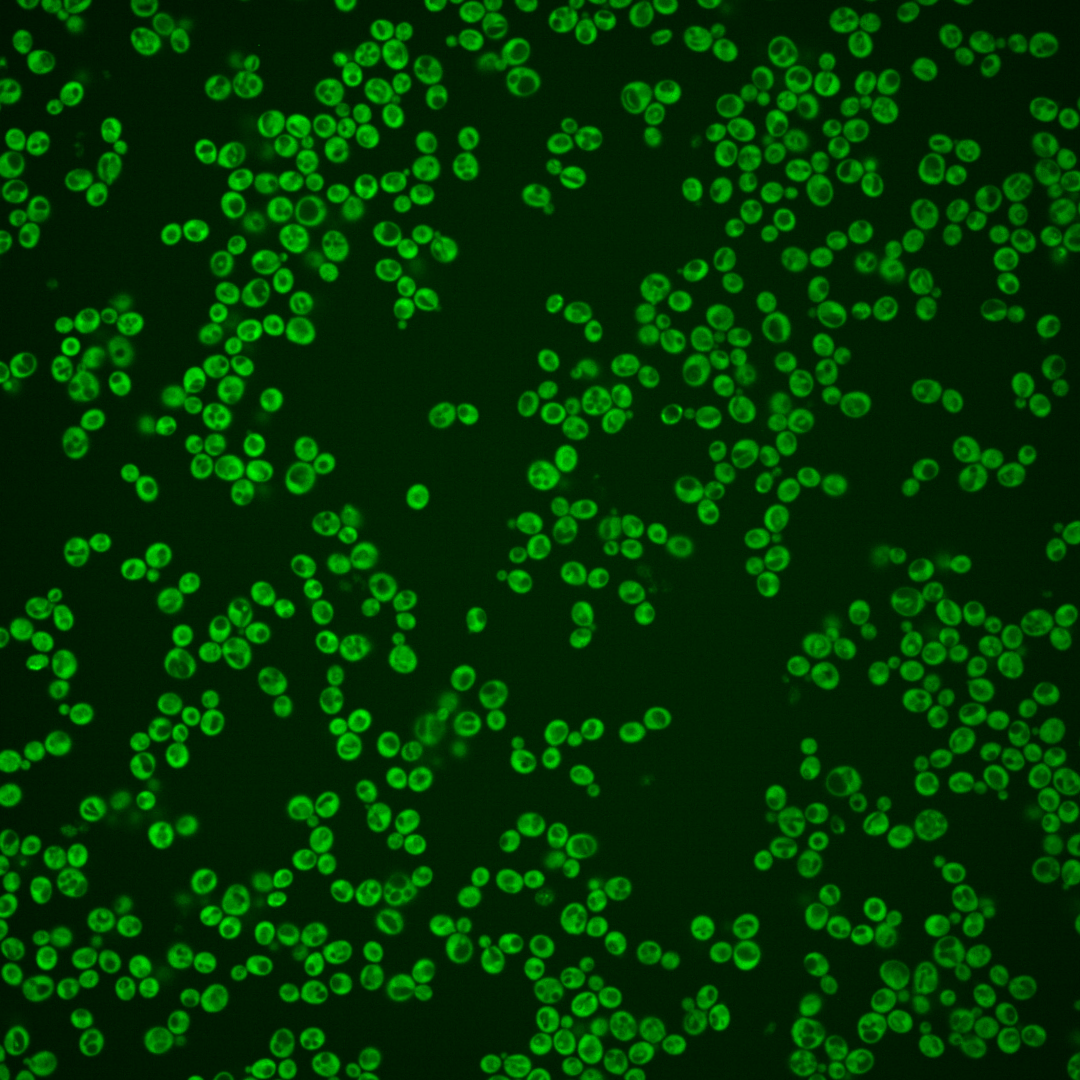
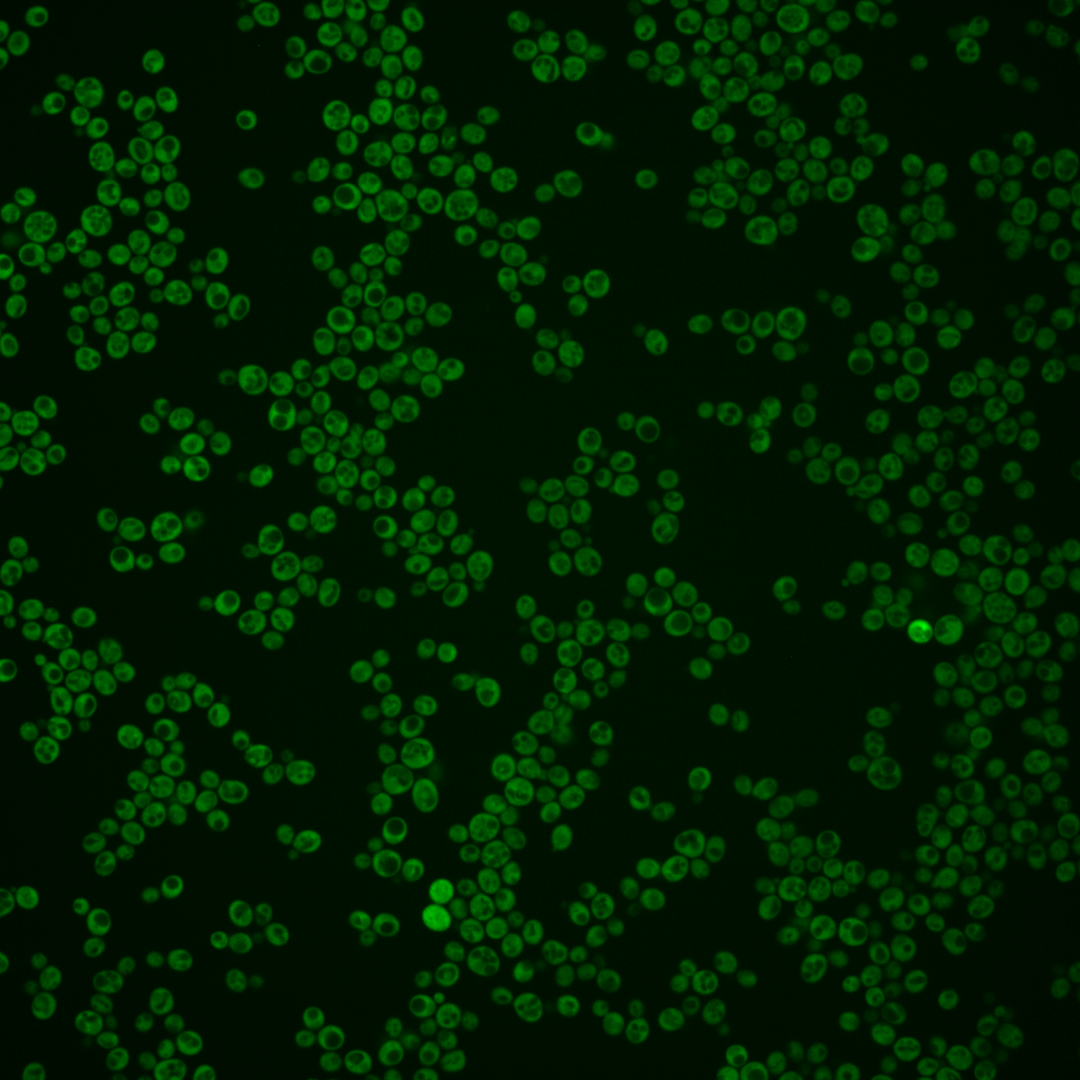
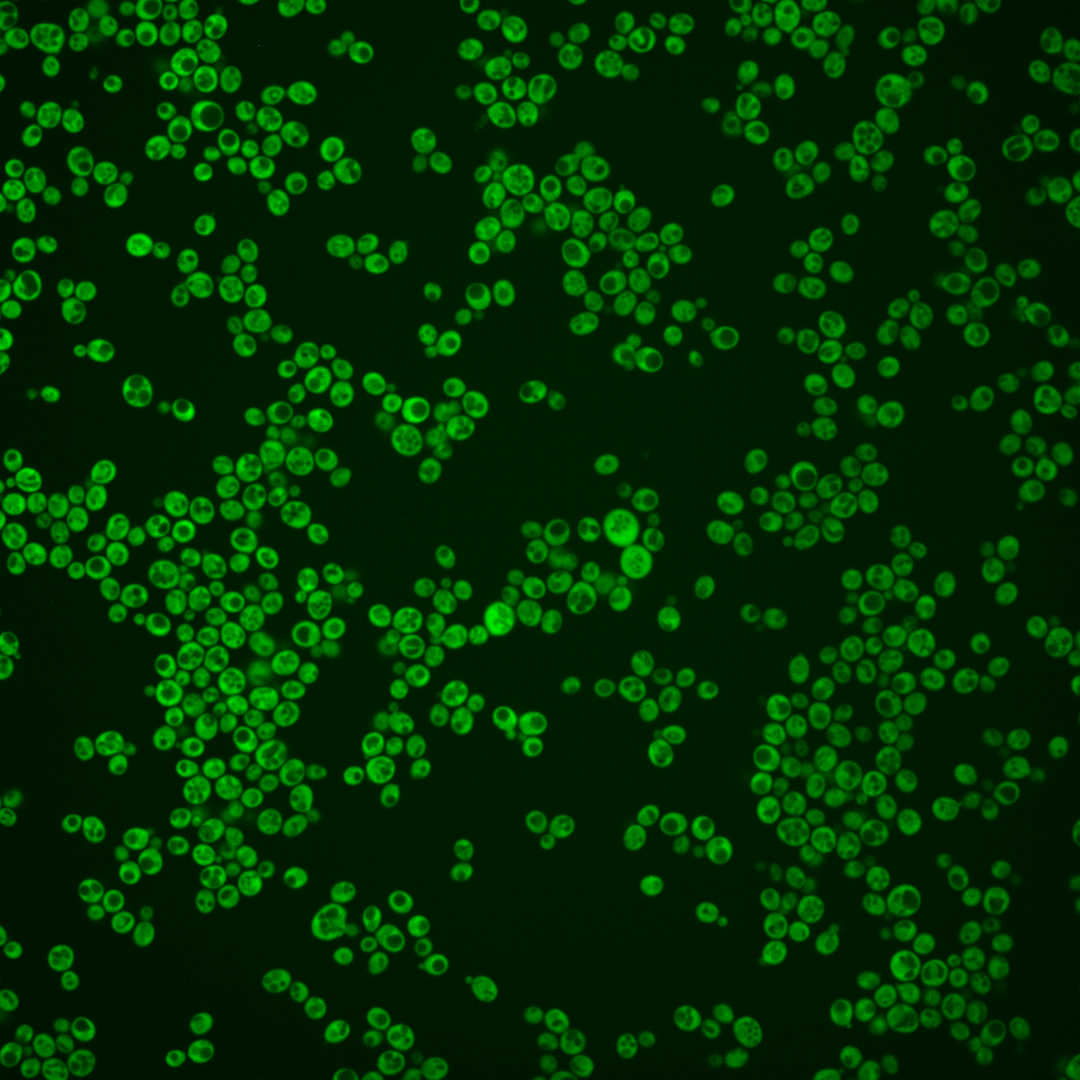
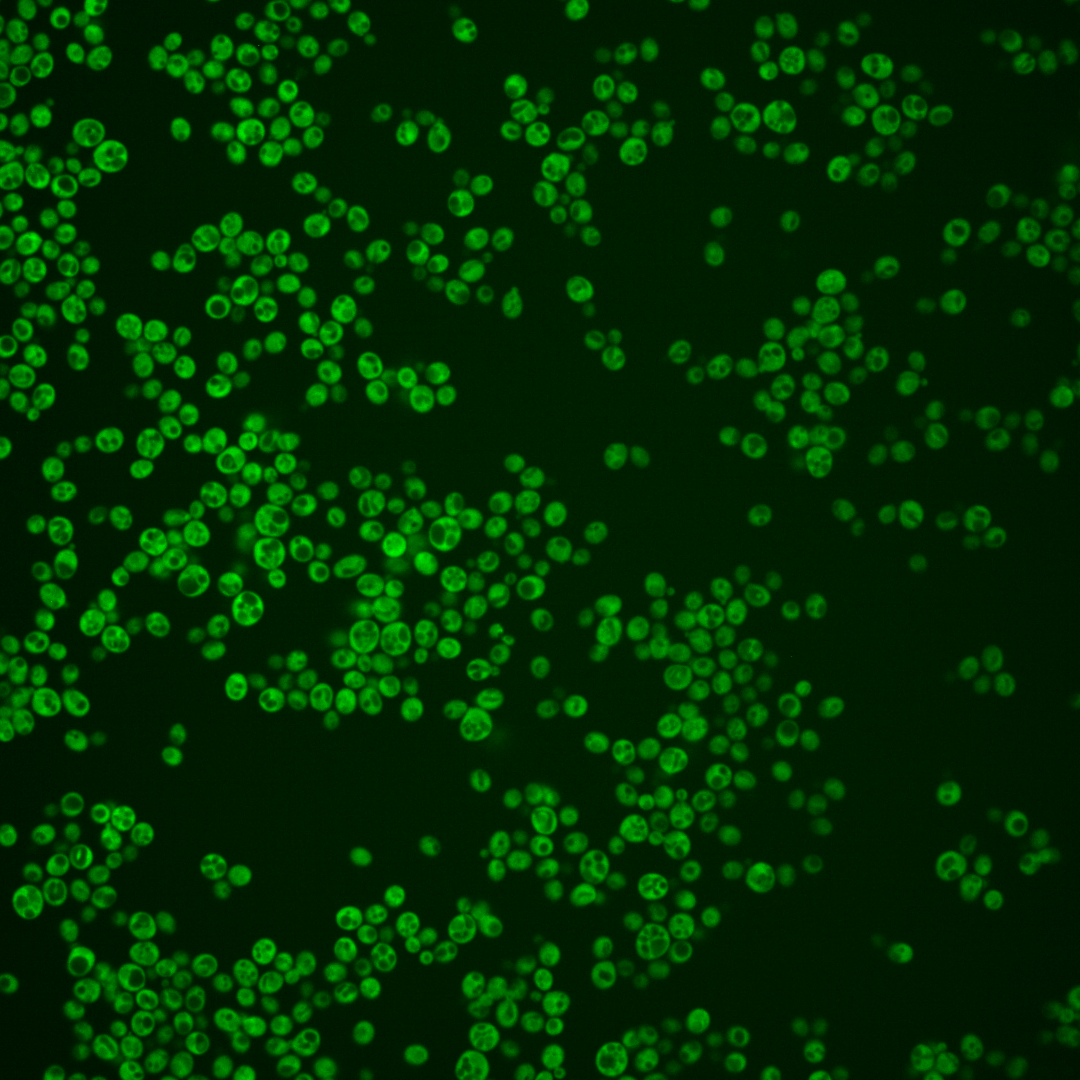
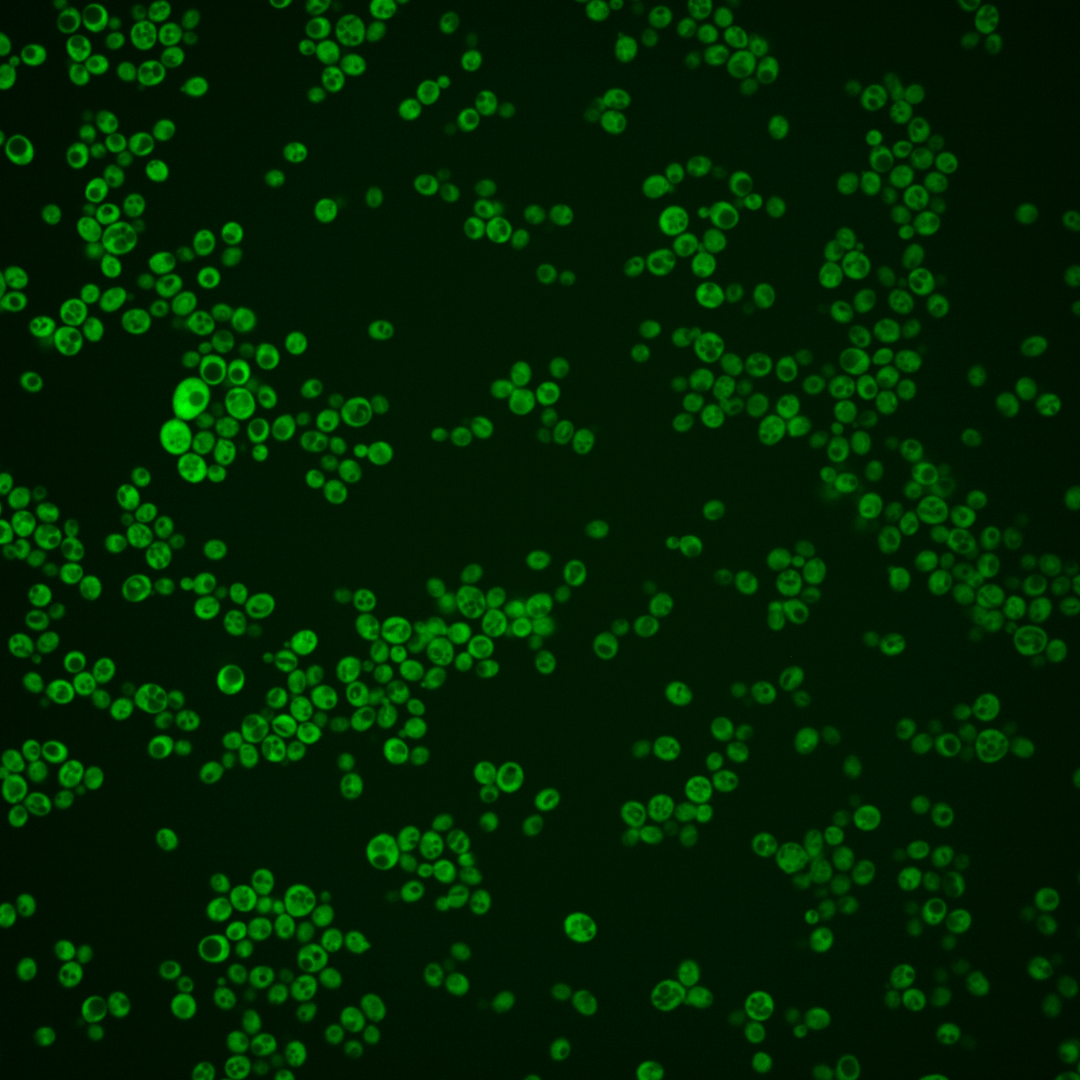

| Standard name | |
|---|---|
| Human Ortholog | |
| Description | Component of RQC, which mediates nascent chain degradation; RQC (ribosome quality control complex) is a ribosome-bound complex required for degradation of polypeptides arising from stalled translation; recruits alanine- and threonine-charged tRNA to the A site and directs the elongation of nascent chains independently of mRNA or 40S subunits; monitors translation stress and signals this to Hsf1p |
Micrographs




















































































Sub-cellular Localization
Yeast GFP Assignment
Protein Abundance
Localization Change
External localization resources
| ensLOC | DeepLoc | |||||||||||||||||||||||
|---|---|---|---|---|---|---|---|---|---|---|---|---|---|---|---|---|---|---|---|---|---|---|---|---|
| Localization | WT1 | WT2 | WT3 | RAP60 | RAP140 | RAP220 | RAP300 | RAP380 | RAP460 | RAP540 | RAP620 | RAP700 | HU80 | HU120 | HU160 | rpd3Δ_1 | rpd3Δ_2 | rpd3Δ_3 | WT1 | WT2 | WT3 | AF100 | AF140 | AF180 |
| Cortical Patches | 0 | 0 | 0 | 0 | 0 | 1 | 5 | 5 | 1 | 5 | 1 | 6 | 0 | 1 | 3 | 0 | 0 | 0 | 0 | 0 | 0 | 0 | 1 | 1 |
| Bud | 0 | 0 | 1 | 3 | 1 | 3 | 9 | 7 | 5 | 11 | 5 | 11 | 0 | 1 | 3 | 0 | 0 | 1 | 0 | 0 | 0 | 0 | 0 | 0 |
| Bud Neck | 0 | 0 | 0 | 0 | 0 | 0 | 0 | 0 | 0 | 0 | 0 | 0 | 0 | 0 | 0 | 0 | 0 | 0 | 0 | 0 | 0 | 0 | 0 | 0 |
| Bud Site | 0 | 0 | 0 | 0 | 0 | 0 | 0 | 0 | 0 | 0 | 0 | 0 | 0 | 0 | 1 | 0 | 0 | 0 | – | – | – | – | – | – |
| Cell Periphery | 6 | 3 | 3 | 8 | 14 | 14 | 24 | 19 | 20 | 24 | 15 | 22 | 12 | 9 | 21 | 28 | 15 | 28 | 0 | 0 | 0 | 0 | 0 | 0 |
| Cytoplasm | 174 | 126 | 146 | 274 | 463 | 306 | 515 | 435 | 252 | 403 | 178 | 278 | 322 | 560 | 587 | 373 | 205 | 441 | 172 | 121 | 151 | 229 | 407 | 403 |
| Endoplasmic Reticulum | 2 | 2 | 2 | 2 | 10 | 11 | 14 | 30 | 20 | 32 | 15 | 25 | 2 | 9 | 15 | 20 | 8 | 20 | 1 | 1 | 4 | 7 | 16 | 31 |
| Endosome | 0 | 0 | 0 | 0 | 0 | 0 | 0 | 0 | 0 | 0 | 0 | 0 | 0 | 0 | 0 | 0 | 0 | 3 | 0 | 0 | 0 | 0 | 0 | 1 |
| Golgi | 0 | 1 | 0 | 0 | 0 | 0 | 0 | 0 | 0 | 0 | 0 | 0 | 1 | 1 | 0 | 1 | 2 | 1 | 0 | 0 | 0 | 0 | 0 | 1 |
| Mitochondria | 0 | 2 | 4 | 6 | 21 | 50 | 133 | 162 | 144 | 236 | 136 | 210 | 0 | 0 | 7 | 3 | 3 | 7 | 0 | 0 | 0 | 0 | 0 | 1 |
| Nucleus | 0 | 0 | 0 | 0 | 0 | 0 | 3 | 4 | 1 | 2 | 0 | 0 | 2 | 0 | 2 | 5 | 0 | 2 | 0 | 0 | 0 | 0 | 1 | 0 |
| Nuclear Periphery | 0 | 0 | 0 | 0 | 0 | 0 | 0 | 1 | 1 | 3 | 1 | 1 | 0 | 0 | 0 | 0 | 0 | 0 | 0 | 0 | 0 | 0 | 0 | 0 |
| Nucleolus | 0 | 0 | 0 | 0 | 0 | 1 | 0 | 1 | 0 | 0 | 0 | 0 | 0 | 0 | 0 | 0 | 0 | 0 | 0 | 0 | 0 | 0 | 0 | 0 |
| Peroxisomes | 0 | 0 | 0 | 0 | 0 | 0 | 0 | 0 | 0 | 0 | 0 | 0 | 0 | 0 | 0 | 0 | 0 | 0 | 0 | 0 | 0 | 0 | 0 | 0 |
| SpindlePole | 0 | 0 | 0 | 0 | 0 | 0 | 0 | 0 | 0 | 0 | 0 | 0 | 0 | 0 | 0 | 0 | 0 | 0 | 0 | 0 | 0 | 0 | 0 | 0 |
| Vac/Vac Membrane | 1 | 0 | 0 | 1 | 0 | 0 | 17 | 59 | 2 | 7 | 4 | 9 | 0 | 1 | 0 | 23 | 1 | 21 | 0 | 3 | 5 | 2 | 6 | 4 |
| Unique Cell Count | 178 | 130 | 148 | 280 | 479 | 337 | 623 | 620 | 366 | 603 | 285 | 446 | 329 | 571 | 607 | 407 | 216 | 490 | 176 | 130 | 163 | 243 | 441 | 451 |
| Labelled Cell Count | 183 | 134 | 156 | 294 | 509 | 386 | 720 | 723 | 446 | 723 | 355 | 562 | 339 | 582 | 639 | 453 | 234 | 524 | 176 | 130 | 163 | 243 | 441 | 451 |
Yeast GFP Assignment
Protein Abundance
| Screen | WT1 | WT2 | WT3 | RAP60 | RAP140 | RAP220 | RAP300 | RAP380 | RAP460 | RAP540 | RAP620 | RAP700 | HU80 | HU120 | HU160 | rpd3Δ_1 | rpd3Δ_2 | rpd3Δ_3 | AF100 | AF140 | AF180 |
|---|---|---|---|---|---|---|---|---|---|---|---|---|---|---|---|---|---|---|---|---|---|
| Mean Cell GFP Intensity (1e-4) | 15.2 | 12.2 | 8.4 | 8.5 | 8.2 | 7.0 | 6.5 | 6.3 | 5.5 | 5.3 | 5.1 | 4.9 | 14.1 | 13.2 | 11.5 | 16.0 | 16.2 | 17.7 | 13.6 | 12.6 | 14.5 |
| Std Deviation (1e-4) | 1.9 | 1.9 | 1.7 | 1.1 | 1.2 | 0.9 | 1.0 | 1.0 | 0.9 | 0.8 | 0.8 | 0.8 | 1.9 | 1.8 | 1.6 | 3.1 | 3.3 | 4.0 | 2.0 | 2.1 | 2.2 |
| Intensity Change (Log2) | – | – | – | 0.02 | -0.04 | -0.27 | -0.37 | -0.43 | -0.63 | -0.66 | -0.71 | -0.77 | 0.74 | 0.65 | 0.45 | 0.93 | 0.95 | 1.07 | 0.69 | 0.59 | 0.78 |
Localization Change
| Localization | RAP60 | RAP140 | RAP220 | RAP300 | RAP380 | RAP460 | RAP540 | RAP620 | RAP700 | HU80 | HU120 | HU160 | rpd3Δ_1 | rpd3Δ_2 | rpd3Δ_3 |
|---|---|---|---|---|---|---|---|---|---|---|---|---|---|---|---|
| Cortical Patches | 0 | 0 | 0 | 0 | 0 | 0 | 0 | 0 | 0 | 0 | 0 | 0 | 0 | 0 | 0 |
| Bud | 0 | 0 | 0 | 0 | 0 | 0 | 0 | 0 | 0 | 0 | 0 | 0 | 0 | 0 | 0 |
| Bud Neck | 0 | 0 | 0 | 0 | 0 | 0 | 0 | 0 | 0 | 0 | 0 | 0 | 0 | 0 | 0 |
| Bud Site | 0 | 0 | 0 | 0 | 0 | 0 | 0 | 0 | 0 | 0 | 0 | 0 | 0 | 0 | 0 |
| Cell Periphery | 0 | 0 | 1.2 | 1.1 | 0 | 1.7 | 1.1 | 1.6 | 1.5 | 0 | 0 | 0 | 2.2 | 2.1 | 1.8 |
| Cytoplasm | -0.6 | -1.3 | -3.2 | -5.0 | -7.3 | -7.3 | -7.8 | -8.2 | -8.5 | -0.6 | -0.5 | -1.3 | -3.0 | -1.9 | -3.4 |
| Endoplasmic Reticulum | 0 | 0 | 0 | 0 | 1.9 | 2.1 | 2.1 | 2.0 | 2.2 | 0 | 0 | 0 | 1.9 | 0 | 1.6 |
| Endosome | 0 | 0 | 0 | 0 | 0 | 0 | 0 | 0 | 0 | 0 | 0 | 0 | 0 | 0 | 0 |
| Golgi | 0 | 0 | 0 | 0 | 0 | 0 | 0 | 0 | 0 | 0 | 0 | 0 | 0 | 0 | 0 |
| Mitochondria | 0 | 0.9 | 3.9 | 5.3 | 6.2 | 8.3 | 8.5 | 9.5 | 9.7 | 0 | 0 | 0 | 0 | 0 | 0 |
| Nucleus | 0 | 0 | 0 | 0 | 0 | 0 | 0 | 0 | 0 | 0 | 0 | 0 | 0 | 0 | 0 |
| Nuclear Periphery | 0 | 0 | 0 | 0 | 0 | 0 | 0 | 0 | 0 | 0 | 0 | 0 | 0 | 0 | 0 |
| Nucleolus | 0 | 0 | 0 | 0 | 0 | 0 | 0 | 0 | 0 | 0 | 0 | 0 | 0 | 0 | 0 |
| Peroxisomes | 0 | 0 | 0 | 0 | 0 | 0 | 0 | 0 | 0 | 0 | 0 | 0 | 0 | 0 | 0 |
| SpindlePole | 0 | 0 | 0 | 0 | 0 | 0 | 0 | 0 | 0 | 0 | 0 | 0 | 0 | 0 | 0 |
| Vacuole | 0 | 0 | 0 | 0 | 3.9 | 0 | 0 | 0 | 0 | 0 | 0 | 0 | 3.0 | 0 | 0 |
External localization resources
Images






























Protein Concentration and Protein Localization Data
| R1 | R2 | R3 | ||||||||||||||||
|---|---|---|---|---|---|---|---|---|---|---|---|---|---|---|---|---|---|---|
| G1 Pre-START | G1 Post-START | S/G2 | Metaphase | Anaphase | Telophase | G1 Pre-START | G1 Post-START | S/G2 | Metaphase | Anaphase | Telophase | G1 Pre-START | G1 Post-START | S/G2 | Metaphase | Anaphase | Telophase | |
| Concentration | 7.4574 | 11.7366 | 10.1166 | 9.307 | 9.883 | 10.3133 | 10.4483 | 15.1396 | 13.7452 | 13.3305 | 10.2525 | 13.6922 | 5.7251 | 8.4584 | 7.6081 | 7.4787 | 7.4164 | 7.5148 |
| Actin | 0.0905 | 0.001 | 0.0233 | 0.002 | 0.003 | 0.0053 | 0.0222 | 0.0067 | 0.0079 | 0.0111 | 0.0081 | 0.0011 | 0.0104 | 0.0028 | 0.0039 | 0.0012 | 0.0004 | 0.0019 |
| Bud | 0.0026 | 0.0006 | 0.0009 | 0.0027 | 0.0006 | 0.0004 | 0.0007 | 0.0027 | 0.0005 | 0.001 | 0.0071 | 0.0002 | 0.0005 | 0.0004 | 0.0006 | 0.0006 | 0.0002 | 0.0003 |
| Bud Neck | 0.0084 | 0.0006 | 0.0015 | 0.0019 | 0.0012 | 0.0056 | 0.0036 | 0.0006 | 0.0009 | 0.0007 | 0.0011 | 0.001 | 0.0008 | 0.0003 | 0.0004 | 0.0006 | 0.0004 | 0.0012 |
| Bud Periphery | 0.0021 | 0.0005 | 0.0008 | 0.0031 | 0.0005 | 0.0007 | 0.0009 | 0.0024 | 0.0002 | 0.001 | 0.0164 | 0.0001 | 0.0004 | 0.0002 | 0.0002 | 0.0002 | 0 | 0.0003 |
| Bud Site | 0.0099 | 0.0015 | 0.0015 | 0.0011 | 0.0002 | 0.0003 | 0.0033 | 0.0096 | 0.0043 | 0.0015 | 0.0017 | 0.0001 | 0.0018 | 0.0009 | 0.0023 | 0.0005 | 0.0002 | 0.0002 |
| Cell Periphery | 0.0015 | 0.0015 | 0.0014 | 0.0006 | 0.0006 | 0.0011 | 0.0007 | 0.0006 | 0.0005 | 0.0003 | 0.0005 | 0 | 0.0009 | 0.0002 | 0.0005 | 0.0001 | 0.0001 | 0.0002 |
| Cytoplasm | 0.6103 | 0.9229 | 0.8042 | 0.8441 | 0.8076 | 0.7961 | 0.754 | 0.9371 | 0.8697 | 0.8209 | 0.722 | 0.9169 | 0.7285 | 0.9124 | 0.8783 | 0.7938 | 0.8803 | 0.8872 |
| Cytoplasmic Foci | 0.0238 | 0.0038 | 0.012 | 0.0188 | 0.0091 | 0.0065 | 0.0165 | 0.0056 | 0.018 | 0.0134 | 0.0122 | 0.0087 | 0.0434 | 0.0146 | 0.0212 | 0.0264 | 0.0201 | 0.0098 |
| Eisosomes | 0.0012 | 0 | 0.0011 | 0 | 0 | 0.0001 | 0.0001 | 0.0001 | 0 | 0.0001 | 0.0001 | 0 | 0.0002 | 0 | 0.0001 | 0 | 0 | 0 |
| Endoplasmic Reticulum | 0.0704 | 0.0378 | 0.0533 | 0.0134 | 0.0719 | 0.0981 | 0.0577 | 0.008 | 0.0149 | 0.0069 | 0.009 | 0.0291 | 0.1221 | 0.0118 | 0.0275 | 0.0167 | 0.0299 | 0.0448 |
| Endosome | 0.0584 | 0.0131 | 0.0391 | 0.0491 | 0.049 | 0.0285 | 0.049 | 0.0078 | 0.0372 | 0.048 | 0.0737 | 0.0254 | 0.0446 | 0.0255 | 0.0339 | 0.1222 | 0.0565 | 0.0259 |
| Golgi | 0.0152 | 0.002 | 0.008 | 0.0043 | 0.0021 | 0.009 | 0.0194 | 0.0035 | 0.0114 | 0.0176 | 0.0237 | 0.0053 | 0.0112 | 0.0131 | 0.0053 | 0.01 | 0.0024 | 0.0046 |
| Lipid Particles | 0.0092 | 0.0001 | 0.0052 | 0.0002 | 0.0004 | 0.0051 | 0.0049 | 0.0004 | 0.004 | 0.009 | 0.0277 | 0.0003 | 0.0041 | 0.0062 | 0.0033 | 0.0003 | 0.0001 | 0.0008 |
| Mitochondria | 0.0097 | 0.0011 | 0.0081 | 0.0177 | 0.0021 | 0.0208 | 0.0136 | 0.0038 | 0.0042 | 0.0127 | 0.0636 | 0.0021 | 0.0017 | 0.003 | 0.0032 | 0.0018 | 0.0004 | 0.0137 |
| None | 0.0119 | 0.0004 | 0.0024 | 0.0011 | 0.0014 | 0.0007 | 0.0018 | 0.0007 | 0.0016 | 0.0006 | 0.0007 | 0.0005 | 0.0064 | 0.0006 | 0.0044 | 0.0009 | 0.0007 | 0.0014 |
| Nuclear Periphery | 0.0123 | 0.0017 | 0.0075 | 0.0039 | 0.0186 | 0.0043 | 0.0164 | 0.0008 | 0.0031 | 0.0024 | 0.0027 | 0.0015 | 0.0081 | 0.0011 | 0.0019 | 0.0016 | 0.001 | 0.0012 |
| Nucleolus | 0.0029 | 0 | 0.0003 | 0.0001 | 0.0001 | 0.0001 | 0.0003 | 0.0006 | 0.0002 | 0.0005 | 0.0003 | 0 | 0.0003 | 0 | 0.0001 | 0 | 0 | 0 |
| Nucleus | 0.0086 | 0.0012 | 0.0047 | 0.0035 | 0.0031 | 0.0017 | 0.0157 | 0.0015 | 0.003 | 0.0019 | 0.0018 | 0.0014 | 0.0023 | 0.0009 | 0.001 | 0.0009 | 0.0007 | 0.0008 |
| Peroxisomes | 0.0167 | 0 | 0.0017 | 0.0006 | 0.0001 | 0.0008 | 0.002 | 0.0005 | 0.0031 | 0.0019 | 0.0025 | 0.0004 | 0.0016 | 0.0027 | 0.0032 | 0.0002 | 0.0001 | 0.0009 |
| Punctate Nuclear | 0.0079 | 0 | 0.0016 | 0.0004 | 0.0007 | 0.0006 | 0.0011 | 0.0001 | 0.0006 | 0.0003 | 0.0004 | 0.0001 | 0.0036 | 0.0003 | 0.0007 | 0.0002 | 0.0001 | 0.0001 |
| Vacuole | 0.0214 | 0.0088 | 0.018 | 0.0248 | 0.0189 | 0.0103 | 0.0134 | 0.0059 | 0.0128 | 0.0401 | 0.0198 | 0.0043 | 0.0056 | 0.0025 | 0.0069 | 0.0163 | 0.0053 | 0.0033 |
| Vacuole Periphery | 0.005 | 0.0013 | 0.0033 | 0.0064 | 0.0087 | 0.0039 | 0.0028 | 0.0011 | 0.002 | 0.0082 | 0.005 | 0.0015 | 0.0015 | 0.0006 | 0.0012 | 0.0054 | 0.0011 | 0.0013 |
Sequencing Data
| R1 | R2 | |||||||||
|---|---|---|---|---|---|---|---|---|---|---|
| G1 Post-START | S/G2 | Metaphase | Anaphase | Telophase | G1 Post-START | S/G2 | Metaphase | Anaphase | Telophase | |
| Gene Expression | 65.3122 | 58.8598 | 70.6808 | 43.0141 | 60.8136 | 82.4353 | 48.7943 | 50.641 | 59.8574 | 47.728 |
| Translational Efficiency | 1.0654 | 0.878 | 0.623 | 1.1912 | 0.8392 | 0.6786 | 0.8271 | 0.732 | 0.626 | 1.0292 |
Hit Data
| Dataset | Hit |
|---|---|
| Protein Concentration | ✘ |
| Protein Localization | ✘ |
| Gene Expression | ✘ |
| Translational Efficiency | ✘ |
Endocytosis
| Temp | Actin Patch (Sac6-tdTomato) | Cortical Patch (Sla1-GFP) | Late Endosome (Snf7-GFP) | Vacuole (Vph1-GFP) |
|---|---|---|---|---|
| 37℃ | ||||
| RT |
Cell Cycle Omics
CYCLoPs (Rqc2-GFP)
| Gene / Allele | Actin Patch (Sac6-tdTomato) | Cortical Patch (Sla1-GFP) | Late Endosome (Snf7-GFP) | Vacuole (Sac6-tdTomato) |
|---|
| Gene | Images |
|---|
| Gene | Images |
|---|
Images are not yet available
Images are not yet available